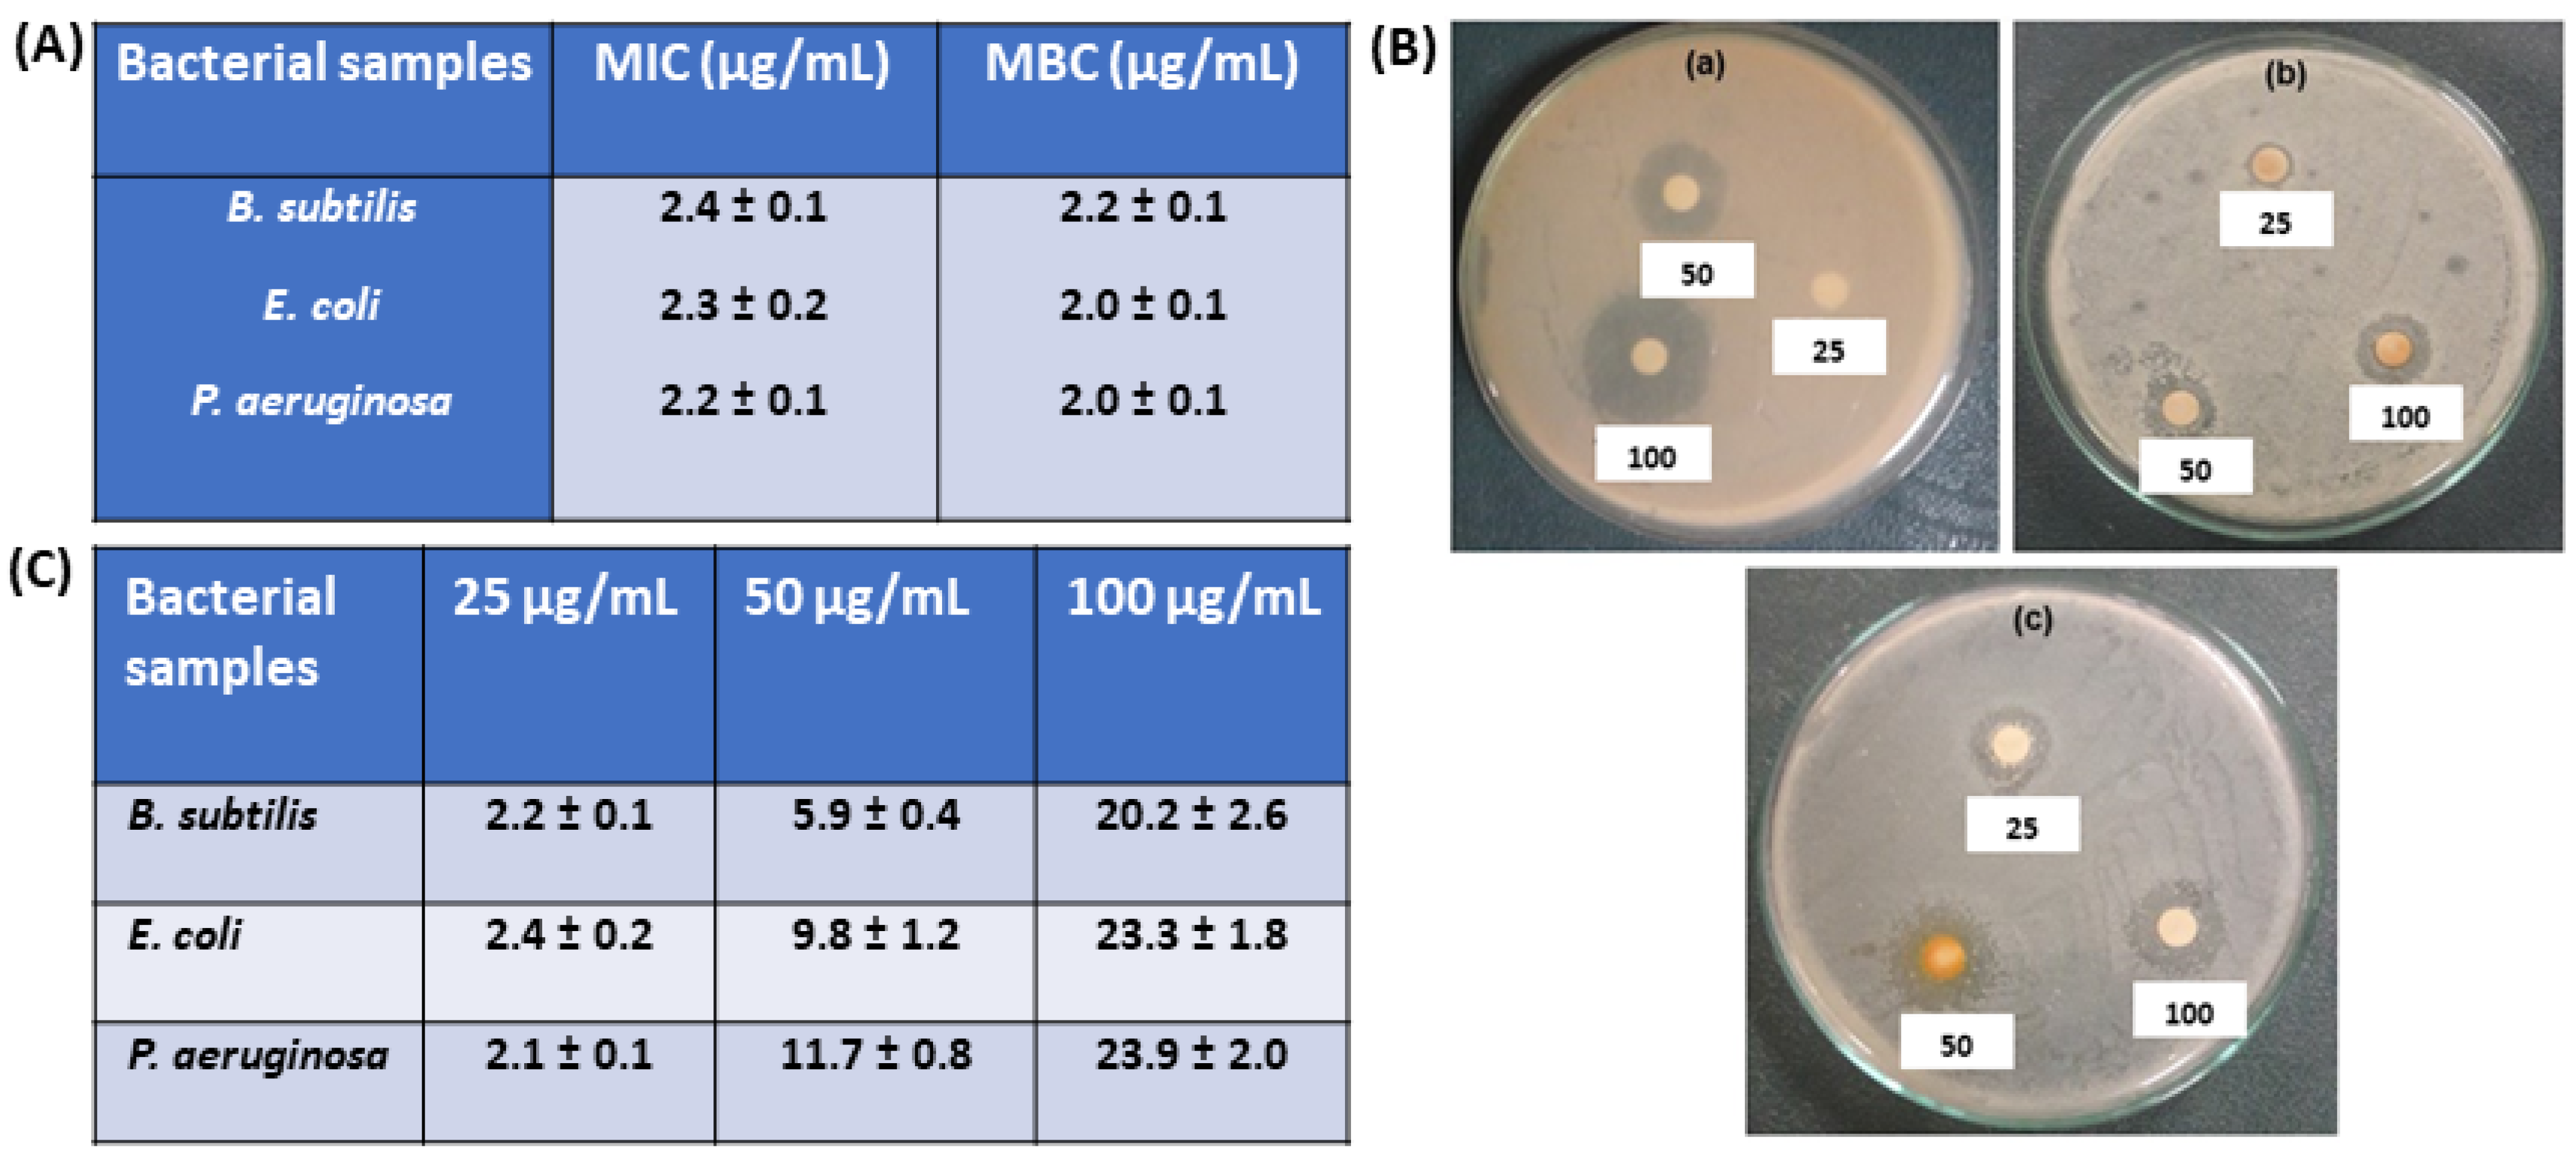
Jcs 05 00267 g004

Synthesis and Characterization of Novel Fe3O4/PVA/Eggshell Hybrid Nanocomposite for Photodegradation and Antibacterial Activity
Abstract
:1. Introduction
2. Materials and Methods
2.1. Synthesis and Physicochemical Characterization of Fe3O4/PVA/Eggshell Hybrid Nanocomposite
2.2. Photodegradation and Antibacterial Activity
3. Results and Discussion
3.1. Synthesis and Physicochemical Characterizations of Fe3O4/PVA/Eggshell Hybrid Nanocomposite
3.2. Photodegradation and Antibacterial Activity
4. Conclusions
Author Contributions
Funding
Institutional Review Board Statement
Informed Consent Statement
Data Availability Statement
Conflicts of Interest
References
- Sudha, D.; Sivakumar, P. Review on the photocatalytic activity of various composite catalysts. Chem. Eng. Process. Process. Intensif. 2015, 97, 112–133. [Google Scholar] [CrossRef]
- Liu, L.; Zhang, X.; Yang, L.; Ren, L.; Wang, D.; Ye, J. Metal nanoparticles induced photocatalysis. Natl. Sci. Rev. 2017, 4, 761–780. [Google Scholar] [CrossRef] [Green Version]
- Chandel, N.; Sharma, K.; Sudhaik, A.; Raizada, P.; Hosseini-Bandegharaei, A.; Thakur, V.K.; Singh, P. Magnetically separable ZnO/ZnFe2O4 and ZnO/CoFe2O4 photocatalysts supported onto nitrogen doped graphene for photocatalytic degradation of toxic dyes. Arab. J. Chem. 2019, 13, 4324–4340. [Google Scholar] [CrossRef]
- Mishra, P.; Patnaik, S.; Parida, K. An overview of recent progress on noble metal modified magnetic Fe3O4 for photocatalytic pollutant degradation and H2 evolution. Catal. Sci. Technol. 2019, 9, 916–941. [Google Scholar] [CrossRef]
- Riva’I, I.; Wulandari, I.O.; Sulistyarti, H.; Sabarudin, A. Ex-Situ Synthesis of Polyvinyl alcohol(PVA)-coated Fe3O4 Nanoparticles by Coprecipitation-Ultrasonication Method. IOP Conf. Ser. Mater. Sci. Eng. 2018, 299, 12065. [Google Scholar] [CrossRef]
- Kim, S.Y.; Ramaraj, B.; Yoon, K.R. Preparation and characterization of polyvinyl alcohol-grafted Fe3O4 magnetic nanoparticles through glutaraldehyde. Surf. Interface Anal. 2012, 44, 1238–1242. [Google Scholar] [CrossRef]
- Amarasinghe, A.; Wanniarachchi, D. Eco-Friendly Photocatalyst Derived from Egg Shell Waste for Dye Degradation. J. Chem. 2019, 2019, 8184732. [Google Scholar] [CrossRef]
- Kumar, A.; Raizada, P.; Hosseini-Bandegharaei, A.; Thakur, V.K.; Nguyen, V.-H.; Singh, P. C-, N-Vacancy defect engineered polymeric carbon nitride towards photocatalysis: Viewpoints and challenges. J. Mater. Chem. A 2020, 9, 111–153. [Google Scholar] [CrossRef]
- Shubha, J.P.; Savitha, H.S.; Adil, S.F.; Khan, M.; Hatshan, M.R.; Kavalli, K.; Shaik, B. Straightforward Synthesis of Mn3O4/ZnO/Eu2O3-Based Ternary Heterostructure Nano-Photocatalyst and Its Application for the Photodegradation of Methyl Orange and Methylene Blue Dyes. Molecules 2021, 26, 4661. [Google Scholar] [CrossRef] [PubMed]
- Ates, B.; Koytepe, S.; Ulu, A.; Gürses, C.; Thakur, V.K. Chemistry, Structures, and Advanced Applications of Nanocomposites from Biorenewable Resources. Chem. Rev. 2020, 120, 9304–9362. [Google Scholar] [CrossRef]
- Raizada, P.; Thakur, P.; Sudhaik, A.; Singh, P.; Thakur, V.K.; Hosseini-Bandegharaei, A. Fabrication of dual Z-scheme photocatalyst via coupling of BiOBr/Ag/AgCl heterojunction with P and S co-doped g-C3N4 for efficient phenol degradation. Arab. J. Chem. 2020, 13, 4538–4552. [Google Scholar] [CrossRef]
- Rokesh, K.; Sakar, M.; Do, T.-O. Emerging Hybrid Nanocomposite Photocatalysts for the Degradation of Antibiotics: Insights into Their Designs and Mechanisms. Nanomaterials 2021, 11, 572. [Google Scholar] [CrossRef] [PubMed]
- Kumar, R.; Raizada, P.; Verma, N.; Hosseini-Bandegharaei, A.; Thakur, V.K.; Van Le, Q.; Nguyen, V.-H.; Selvasembian, R.; Singh, P. Recent advances on water disinfection using bismuth based modified photocatalysts: Strategies and challenges. J. Clean. Prod. 2021, 297, 126617. [Google Scholar] [CrossRef]
- Hasija, V.; Raizada, P.; Sudhaik, A.; Sharma, K.; Kumar, A.; Singh, P.; Jonnalagadda, S.B.; Thakur, V.K. Recent advances in noble metal free doped graphitic carbon nitride based nanohybrids for photocatalysis of organic contaminants in water: A review. Appl. Mater. Today 2019, 15, 494–524. [Google Scholar] [CrossRef]
- Sharma, S.; Dutta, V.; Singh, P.; Raizada, P.; Rahmani-Sani, A.; Hosseini-Bandegharaei, A.; Thakur, V.K. Carbon quantum dot supported semiconductor photocatalysts for efficient degradation of organic pollutants in water: A review. J. Clean. Prod. 2019, 228, 755–769. [Google Scholar] [CrossRef]
- Jia, J.; Liu, G.; Yu, J.; Duan, Y. Preparation and Characterization of Soluble Eggshell Membrane Protein/PLGA Electrospun Nanofibers for Guided Tissue Regeneration Membrane. J. Nanomater. 2012, 2012, 25. [Google Scholar] [CrossRef] [Green Version]
- Wang, Q.; Ma, C.; Tang, J.; Zhang, C.; Ma, L. Eggshell Membrane-Templated MnO2 Nanoparticles: Facile Synthesis and Tetracycline Hydrochloride Decontamination. Nanoscale Res. Lett. 2018, 13, 255. [Google Scholar] [CrossRef]
- Sheish, S.G.; Emadi, R.; Ahmadian, M.; Sadeghzade, S.; Tavangarian, F. Fabrication and Characterization of Polyvinylpyrrolidone-Eggshell Membrane-Reduced Graphene Oxide Nanofibers for Tissue Engineering Applications. Polymers 2021, 13, 913. [Google Scholar] [CrossRef]
- Zheng, B.; Xie, S.; Qian, L.; Yuan, H.; Xiao, D.; Choi, M.M.F. Gold nanoparticles-coated eggshell membrane with immobilized glucose oxidase for fabrication of glucose biosensor. Sens. Actuators B Chem. 2011, 152, 49–55. [Google Scholar] [CrossRef]
- Nasrollahzadeh, M.; Sajadi, S.M.; Hatamifard, A. Waste chicken eggshell as a natural valuable resource and environmentally benign support for biosynthesis of catalytically active Cu/eggshell, Fe3O4/eggshell and Cu/Fe3O4/eggshell nanocomposites. Appl. Catal. B Environ. 2016, 191, 209–227. [Google Scholar] [CrossRef]
- Guo, Y.; Yang, D.-P.; Liu, M.; Zhang, X.; Chen, Y.; Huang, J.; Li, Q.; Luque, R. Enhanced catalytic benzene oxidation over a novel waste-derived Ag/eggshell catalyst. J. Mater. Chem. A 2018, 7, 8832–8844. [Google Scholar] [CrossRef]
- Ahmadi, S.; Chia, C.-H.; Zakaria, S.; Saeedfar, K.; Asim, N. Synthesis of Fe3O4 nanocrystals using hydrothermal approach. J. Magn. Magn. Mater. 2012, 324, 4147–4150. [Google Scholar] [CrossRef]
- Wayane, P. Performance Standard for Antimicrobial Susceptibility Testing; 26th Informational Supplement; Clinical and Laboratory Standards Institute (CLSI): Wayne, PA, USA, 2016; Volume 33, p. M100-S23.
- Senthilkumar, P.; Surendran, L.; Sudhagar, B.; Kumar, D.S.R.S.; Bupesh, G. Hydrothermal assisted Eichhornia crassipes mediated synthesis of magnetite nanoparticles (E-Fe3O4) and its antibiofilm activity. Mater. Res. Express 2019, 6, 095405. [Google Scholar]
- Takai, Z.I.; Mustafa, M.; Asman, S. Preparation of High-Performance Conductive Polyaniline Magnetite (PANI/Fe3O4) Nanocomposites by Sol-Gel Method. Asian J. Chem. 2018, 30, 2625–2630. [Google Scholar] [CrossRef]
- Zhang, P.; Han, Q.; Fan, M.; Jiang, P. Magnetic solid base catalyst CaO/CoFe2O4 for biodiesel production: Influence of basicity and wettability of the catalyst in catalytic performance. Appl. Surf. Sci. 2014, 317, 1125–1130. [Google Scholar] [CrossRef]
- Helwani, Z.; Ramli, M.; Saputra, E.; Bahruddin, B.; Yolanda, D.; Fatra, W.; Idroes, G.M.; Muslem, M.; Mahlia, T.M.I.; Idroes, R. Impregnation of CaO from Eggshell Waste with Magnetite as a Solid Catalyst (Fe3O4/CaO) for Transesterification of Palm Oil Off-Grade. Catalysts 2020, 10, 164. [Google Scholar] [CrossRef] [Green Version]
- Mosaddegh, E.; Hosseininasab, F.A.; Hassankhani, A. Eggshell/Fe3O4 nanocomposite: Novel magnetic nanoparticles coated on porous ceramic eggshell waste as an efficient catalyst in the synthesis of 1,8-dioxo-octahydroxanthene. RSC Adv. 2015, 5, 106561–106567. [Google Scholar] [CrossRef]
- Andrade, G.; Barbosa-Stancioli, E.F.; Mansur, A.A.P.; Vasconcelos, W.L.; Mansur, H.S. Design of novel hybrid organic–inorganic nanostructured biomaterials for immunoassay applications. Biomed. Mater. 2006, 1, 221–234. [Google Scholar] [CrossRef] [PubMed]
- Nasrollahzadeh, M.; Atarod, M.; Sajadi, S.M. Green synthesis of the Cu/Fe3O4 nanoparticles using Morinda morindoides leaf aqueous extract: A highly efficient magnetically separable catalyst for the reduction of organic dyes in aqueous medium at room temperature. Appl. Surf. Sci. 2016, 364, 636–644. [Google Scholar] [CrossRef]
- Senthilkumar, P.; Kumar, D.S.R.S.; Sudhagar, B.; Vanthana, M.; Parveen, M.H.; Sarathkumar, S.; Thomas, J.C.; Mary, A.S.; Kannan, C. Seagrass-mediated silver nanoparticles synthesis by Enhalus acoroides and its α-glucosidase inhibitory activity from the Gulf of Mannar. J. Nanostruct. Chem. 2016, 6, 275–280. [Google Scholar] [CrossRef] [Green Version]
- Sathishkumar, G.; Logeshwaran, V.; Sarathbabu, S.; Jha, P.; Jeyaraj, M.; Kuberan, R.; Senthilkumar, N.; Sivaramakrishnan, S. Green synthesis of magnetic Fe3O4 nanoparticles using Couroupita guianensis Aubl. fruit extract for their antibacterial and cytotoxicity activities. Artif. Cells Nanomed. Biotechnol. 2017, 46, 589–598. [Google Scholar] [CrossRef] [Green Version]
- Issa, B.; Obaidat, I.M.; Albiss, B.A.; Haik, Y. Magnetic Nanoparticles: Surface Effects and Properties Related to Biomedicine Applications. Int. J. Mol. Sci. 2013, 14, 21266–21305. [Google Scholar] [CrossRef] [Green Version]
- Haldorai, Y.; Shim, J.-J. Chitosan-Zinc Oxide hybrid composite for enhanced dye degradation and antibacterial activity. Compos. Interfaces 2013, 20, 365–377. [Google Scholar] [CrossRef]
- Amano, F.; Ishinaga, E.; Yamakata, A. Effect of Particle Size on the Photocatalytic Activity of WO3 Particles for Water Oxidation. J. Phys. Chem. C 2013, 117, 22584–22590. [Google Scholar] [CrossRef]
- Wu, H.; Zhang, J. Chitosan-based zinc oxide nanoparticle for enhanced anticancer effect in cervical cancer: A physicochemical and biological perspective. Saudi Pharm. J. 2017, 26, 205–210. [Google Scholar] [CrossRef]
- Arakha, M.; Pal, S.; Samantarrai, D.; Panigrahi, T.K.; Mallick, B.C.; Pramanik, K.; Mallick, B.; Jha, S. Antimicrobial activity of iron oxide nanoparticle upon modulation of nanoparticle-bacteria interface. Sci. Rep. 2015, 5, 14813. [Google Scholar] [CrossRef] [Green Version]
- Naeimi, H.; Nazifi, Z.S.; Amininezhad, S.M. Preparation of Fe3O4 encapsulated-silica sulfonic acid nanoparticles and study of their in vitro antimicrobial activity. J. Photochem. Photobiol. B Biol. 2015, 149, 180–188. [Google Scholar] [CrossRef]
- Sangeetha, J.; Philip, J. Synthesis, characterization and antimicrobial property of Fe3O4-Cys-HNQ nanocomplex, with L-cysteine molecule as a linker. RSC Adv. 2013, 3, 8047–8057. [Google Scholar] [CrossRef]
- Shaikh, S.; Nazam, N.; Rizvi, S.M.D.; Ahmad, K.; Baig, M.H.; Lee, E.J.; Choi, I. Mechanistic Insights into the Antimicrobial Actions of Metallic Nanoparticles and Their Implications for Multidrug Resistance. Int. J. Mol. Sci. 2019, 20, 2468. [Google Scholar] [CrossRef] [Green Version]
- Tharani, S.; Bharathi, D.; Ranjithkumar, R. Extracellular green synthesis of chitosan-silver nanoparticles using Lactobacillus reuteri for antibacterial applications. Biocatal. Agric. Biotechnol. 2020, 30, 101838. [Google Scholar] [CrossRef]

Publisher’s Note: MDPI stays neutral with regard to jurisdictional claims in published maps and institutional affiliations. |
© 2021 by the authors. Licensee MDPI, Basel, Switzerland. This article is an open access article distributed under the terms and conditions of the Creative Commons Attribution (CC BY) license (https://creativecommons.org/licenses/by/4.0/).
Share and Cite
Gupta, P.K.; Palanisamy, S.; Gopal, T.; Rajamani, R.; Pandit, S.; Sinha, S.; Thakur, V.K. Synthesis and Characterization of Novel Fe3O4/PVA/Eggshell Hybrid Nanocomposite for Photodegradation and Antibacterial Activity. J. Compos. Sci. 2021, 5, 267. https://doi.org/10.3390/jcs5100267
Gupta PK, Palanisamy S, Gopal T, Rajamani R, Pandit S, Sinha S, Thakur VK. Synthesis and Characterization of Novel Fe3O4/PVA/Eggshell Hybrid Nanocomposite for Photodegradation and Antibacterial Activity. Journal of Composites Science. 2021; 5(10):267. https://doi.org/10.3390/jcs5100267
Chicago/Turabian StyleGupta, Piyush Kumar, Senthilkumar Palanisamy, Tamilarasi Gopal, Ranjithkumar Rajamani, Soumya Pandit, Somya Sinha, and Vijay Kumar Thakur. 2021. "Synthesis and Characterization of Novel Fe3O4/PVA/Eggshell Hybrid Nanocomposite for Photodegradation and Antibacterial Activity" Journal of Composites Science 5, no. 10: 267. https://doi.org/10.3390/jcs5100267
APA StyleGupta, P. K., Palanisamy, S., Gopal, T., Rajamani, R., Pandit, S., Sinha, S., & Thakur, V. K. (2021). Synthesis and Characterization of Novel Fe3O4/PVA/Eggshell Hybrid Nanocomposite for Photodegradation and Antibacterial Activity. Journal of Composites Science, 5(10), 267. https://doi.org/10.3390/jcs5100267

